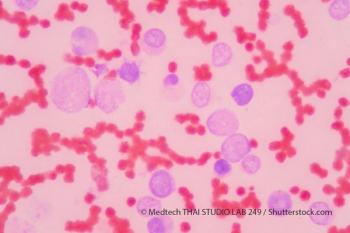

This study examined the acquired resistance found from treatment with third-generation EGFR TKIs to see if it was associated with diverse pathways, with an eye for the EGFR T790M mutation.

This study examined the acquired resistance found from treatment with third-generation EGFR TKIs to see if it was associated with diverse pathways, with an eye for the EGFR T790M mutation.

A study analyzed a test for specific gene patterns that could indicate that a patient will not respond to standard treatment for newly diagnosed multiple myeloma.
Genentech recently announced their phase III study resulted in improved overall survival and composite complete remission rates for patients with previously untreated acute myeloid leukemia.

This study examined the association of disease progression and the deterioration of health-related quality of life for patients with metastatic breast, pancreatic, lung, and colorectal cancer.

Researchers analyzed a patient population with stage IV melanoma and found no difference in the rate of surgical resection with the use of immunotherapy between the checkpoint inhibitor era and pre-checkpoint inhibitor era.

This study found significant increases in the first year, which eventually decreased in following years, regarding sickness absence and disability pensions days after a 2010 breast cancer diagnosis.

The Miami Cancer Institute is one of the leading organizations in diversity amongst its clinical trials, and chief research officer Scott Lipkin, DPM, CIP, spoke on the present and future of diversity within the organization.

Janssen Pharmaceutical Companies recently announced the FDA granted breakthrough therapy designation to JNJ-61186372, an EGFR-MET bispecific antibody, for the treatment of metastatic non-small cell lung cancer with EGFR exon 20 mutations.

A study showed that adolescents and young adults with certain types of cancers saw significant improvements in their 5-year mortality rates, while other cancer types saw little to no significant improvement among the same demographic group.

A recent study found that young women aged 18-39 diagnosed with breast cancer typically suffer through financial hardships regardless of outstanding life circumstances such as career and insurance coverage.

This study examined both cachexia-inducing factors and patients with various cancers to better understand the disparity between cancer types and developing cachexia.

A study published in Cancer suggests meeting the ACS guidelines for physical activity correlates with improved health-related quality of life and lower depression levels.

Kura Oncology’s leading drug candidate, tipifarnib, was granted fast track designation by the FDA to treat adults of T-cell lymphomas.

LUNGevity Foundation released a Lung Cancer Scorecard to examine how effectively (or ineffectively) states are addressing lung cancer.

The FDA recently granted priority review to Takeda’s supplemental new drug application for brigatinib to treat ALK-positive metastatic non-small cell lung cancer.

Roche recently announced the FDA accepted their supplemental biologics license application and granted priority review to atezolizumab for the treatment of non-small cell lung cancer.

The FDA granted a priority review to a new drug application submitted by Seattle Genetics, Inc. for tucatinib to treat patients with HER2-positive breast cancer.

The FDA granted a priority review to Deciphera Pharmaceuticals’ new drug application for ripretinib to treat patients with advanced gastrointestinal stromal tumors.

Bristol-Meyers Squibb Company announced that the FDA granted a priority review to its BLA for liso-cel to treat patients with relapsed or refractory large B-cell lymphoma.

A recent study determined circulating tumor cells were associated with melanoma relapse, suggesting that this form of liquid biopsy could help identify patients who would benefit from adjuvant therapy.

Janssen Pharmaceutical Companies submitted a supplemental biologics license application for daratumumab in combination with carfilzomib and dexamethasone to treat patients with relapsed/refractory multiple myeloma.

The FDA granted a priority review to capmatinib, a MET inhibitor being analyzed for the first-line treatment of previously treated patients with METex14-mutated advanced NSCLC.

A recent study found that patients with stage III breast cancer did not benefit from high-dose chemotherapy, nor did it impact long-term risks of major cardiovascular events.

Calibr received approval from the FDA to move forward with an investigational new drug to treat relapsed/refractory B-cell malignancies with a switchable CAR T-cell therapy.

A recent study suggests older women with estrogen receptor-positive, clinically node-negative, early-stage breast cancer can omit axillary surgery, while nodal positivity declines with advancing age.

A recent study showed survivors aged 60 and older of newly diagnosed nonmetastatic breast cancer reported lower levels of overall well-being and higher levels of symptom burden because of cancer and its treatment.

Treating head and neck cancer with selective neck dissection showed an improvement in shoulder function when level 2b neck dissection was omitted in treatment, according to a recent study.

A recent study suggested the activation of apelin/APJ signaling decreased efficacy in VEGF treatment, while bevacizumab decreased disease-free survival rates with increased expression of apelin in patients of ovarian cancer.

Medicare beneficiaries saw unfavorable results when compared to clinical trial participants being treated with idelalisib for their follicular lymphoma or chronic lymphocytic leukemia.

A recent study shows the importance of information regarding adverse events of cancer treatment for prospective patients.